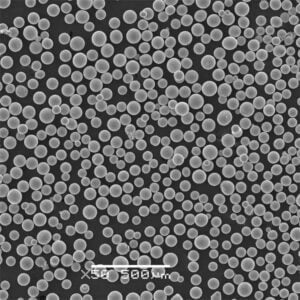
Metal Powders

EIGA Electrode Induction Gas Atomization Equipment
EIGA equipment is mainly used for active and refractory metal or alloy powders, such as titanium and titanium alloys, superalloys, platinum-rhodium alloys, intermetallic compounds, etc. The powders are widely applied in selective laser melting, laser melting deposition, electron beam selected area melting, powder metallurgy, etc.
Application Area
Aerospace
Health
Tooling
Automobile
Machinery
New Energy
Electronics








Technical characteristics
High Sphericity
EIGA equipment achieves high sphericity in powder particles through crucible-free, non-contact melting, eliminating contamination and ensuring uniformity.
Fast Cooling Speed
With a rapid cooling rate, EIGA equipment achieves droplet cooling solidification rates of 103~106K/s, resulting in fine microcrystalline structures within the solidified droplets.
High Purity
Alloys are refined under vacuum conditions in EIGA equipment, resulting in low gas and impurity content in the final powder product, enhancing purity and material properties.
High Powder Quality
Utilizing tightly coupled or free aerosol nozzle technology, EIGA equipment ensures high sphericity and offers control over particle size, leading to superior powder quality and consistency.
Simple Operation
EIGA equipment is designed for easy operation, with short preparation times ideal for continuous mass production, streamlining processes and maximizing efficiency
Energy-Efficient Design
EIGA equipment incorporates energy-efficient features, such as optimized induction heating and gas atomization processes, minimizing energy consumption and reducing operational costs.
Suitable Materials: Titanium-based Alloys
Pulverizing Characteristics
High Powder Yield
EIGA equipment efficiently converts raw materials into fine powder particles, maximizing production output and resource utilization.
High Purity
With minimal impurities and low oxygen content, EIGA-produced powder meets stringent quality standards, enhancing material properties.
Good Sphericity
Powder particles generated by EIGA equipment exhibit uniform flow characteristics, aiding consistent powder distribution in downstream processes.
Excellent Overall Performance
EIGA equipment combines high yield, purity, and sphericity, meeting diverse industrial needs effectively.
Particle Size Control
Precise control over particle size distribution, ranging from 0 to 150 micrometers, ensures versatility and adaptability to specific requirements.
Customizable Parameters
EIGA equipment offers customizable parameters and settings, allowing for fine-tuning of the pulverization process to meet specific material and application requirements.
Technical Parameter
| Induction Electrode Diameter | 30~75mm |
| Induction Electrode Length |
200~1000mm (customization allowed)
|
| Maximum Temperature | 2200℃ |
| Power | 60~120KW |
| Working Vacuum Degree | 6.67×10-3Pa |
| Ultimate Vacuum Degree | 6.67×10-1Pa |
| Pressure Rise Rate | ≤3Pa/h |
| Atomizing Gas Pressure |
0~6MPa, Nozzle: 8MPa
|
| Atomizing Gas Flow |
10~35Nm3/min
|
| Size Distribution |
15~53μm, 53~150μm, 75~200μm, 100~250μm
|
| Build Size |
Depending on the type of furnace
|

FAQ of EIGA equipment
What is EIGA equipment?
EIGA equipment is a specialized system used for the production of alloy metal powders through a process that involves electrode induction melting of the metal followed by gas atomization to form fine powder particles.
How does EIGA equipment work?
EIGA equipment works by melting the desired metal using electrode induction heating. Once the metal reaches a molten state, gas is introduced to atomize the molten metal into fine droplets, which rapidly solidify into powder particles as they cool.
What materials can be processed with EIGA equipment?
EIGA equipment is versatile and can process a wide range of materials, including various alloy compositions and metals such as stainless steel, die steel, superalloys, cobalt-chromium alloys, and aluminum alloys.
What are the advantages of using EIGA equipment?
Some advantages of EIGA equipment include high powder yield, high purity with low oxygen content, good sphericity of powder particles, excellent overall performance, and precise control over particle size distribution.
Is EIGA equipment suitable for mass production?
Yes, EIGA equipment is designed for continuous mass production of alloy metal powders. Its efficiency, throughput, and customizable parameters make it well-suited for industrial-scale production.
How does EIGA equipment ensure powder quality and purity?
EIGA equipment employs advanced technologies such as electrode induction melting and gas atomization under controlled conditions, ensuring high powder quality, purity, and consistency.
Can EIGA equipment be customized for specific powder requirements?
Yes, EIGA equipment often allows for customization of various parameters and settings to meet specific powder requirements and production needs, providing flexibility to adapt to different applications.
Is training provided for operating EIGA equipment?
Many suppliers of EIGA equipment offer training programs for operators to ensure safe and efficient operation of the equipment. These training programs typically cover equipment operation, maintenance procedures, safety protocols, and troubleshooting techniques.